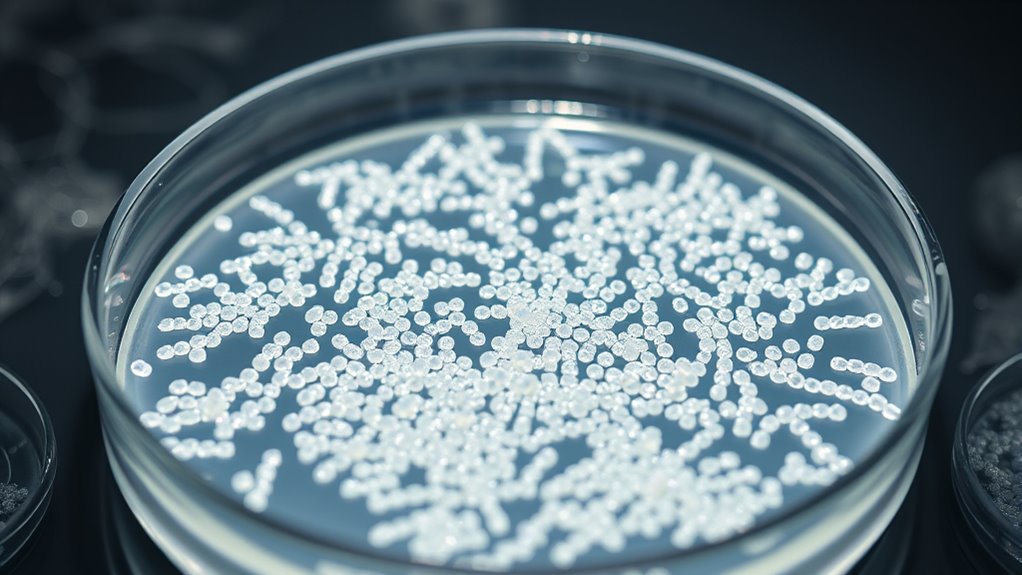
Breitband-antibakterielle Nanopartikelaktivität

MgO-Nanopartikel bieten starke antibakterielle Wirkungen, indem sie bakterielle Membranen physisch schädigen und reaktive Sauerstoffspezies, oder ROS, erzeugen, welche die Zellfunktionen stören. Ihre Wirksamkeit hängt von der verwendeten Konzentration ab; höhere Dosen führen zu schnellerer und vollständigerer bakterieller Hemmung bei vielen Krankheitserregern, einschließlich widerstandsfähiger Stämme wie MRSA und E. coli. Die Art ihrer Herstellung beeinflusst ihre Größe und Oberflächenchemie, was ihre Aktivität weiter steigert. Eine genauere Untersuchung zeigt, wie man ihre Superkraft sicher und effizient maximieren kann.
Wichtigste Erkenntnisse
- MgO-Nanopartikel zeigen eine breitbandige antibakterielle Wirkung durch Membranschädigung und ROS-Generation, wodurch ihre Fähigkeit zur mikrobiellen Eliminierung verbessert wird.
- Die antibakterielle Wirksamkeit hängt von der MgO-Konzentration ab, wobei höhere Dosen größere Hemmungszonen und höhere Eliminationsraten erzielen.
- Synthesemethoden beeinflussen die Größe, Morphologie und Oberflächenchemie der Nanopartikel, was sich direkt auf ihre antibakterielle Wirksamkeit auswirkt.
- Kleinere MgO-Nanopartikel (~21 nm) mit hoher Oberfläche verbessern die Interaktion mit bakteriellen Membranen und die Induktion oxidativen Stresses.
- Ein Gleichgewicht zwischen wirksamen MgO-Dosen und Toxizitätsgrenzen (unter 250 μg/mL) optimiert die antibakteriellen Vorteile bei gleichzeitiger Minimierung von Umwelt- und Gesundheitsrisiken.
Top picks for "antibakterielle superkraft verst"
Open Amazon search results for this keyword.
As an affiliate, we earn on qualifying purchases.
Die antibakterielle Wirksamkeit von MgO-Nanopartikeln: Ein Überblick

MgO-Nanopartikel (MgO-NPs) gewinnen aufgrund ihrer potenten antibakteriellen Eigenschaften zunehmend an Aufmerksamkeit, die durch mehrere Mechanismen entstehen. Wenn Sie MgO-NPs begegnen, sollten Sie wissen, dass sie bakterielle Zellmembranen schädigen, was zu Leckagen und zum Zelltod führt. Sie erzeugen auch reaktive Sauerstoffspezies (ROS), wie Superoxid-Ionen, die die Peptidbindungen in den Membranen stören, insbesondere bei Bakterien wie *E. coli* und *Pseudomonas aeruginosa*. Dank ihrer Nanogröße und hohen Oberfläche interagieren MgO-NPs effizient mit bakteriellen Zellen, was zu physikalischer Zerstörung und oxidativem Stress führt. Diese Effekte können je nach Konzentration und Bakterienart bakterizid oder bakteriostatisch sein. Wichtig ist, dass ihre antibakterielle Wirkung nicht nur durch die Freisetzung von Magnesiumionen entsteht, sondern hauptsächlich durch oxidativen Stress und mechanische Schäden, was sie zu einem vielseitigen antimikrobiellen Mittel macht. Ihre kleine Größe ermöglicht eine effektivere Zellpenetration. Zudem erhöht die hohe Oberfläche der MgO-NPs ihre Reaktivität und Interaktion mit bakteriellen Membranen, was ihre antimikrobielle Wirksamkeit weiter steigert.
Wie MgO-Konzentrationen die Hemmung und Abtötungsraten von Bakterien beeinflussen

Sie werden feststellen, dass eine Erhöhung des MgO-Gehalts im Allgemeinen die bakterielle Hemmung und Abtötungsraten verbessert. Höhere Dosen führen zu größeren Hemmungszonen und einer wirksameren Reduktion der Bakterien, wobei die Effekte je nach Bakterienstamm und Qualität der Nanopartikel variieren. Das Verständnis dieser dosisabhängigen Reaktionen hilft dabei, den Einsatz von MgO für antimicrobiellen Anwendungen zu optimieren. Zusätzlich beeinflussen die Größe und Oberfläche der MgO-Nanopartikel deren antibakterielle Wirksamkeit, wobei kleinere Partikel eine größere Kontaktfläche und Reaktivität bieten. Aspekte wie Partikelverteilung spielen ebenfalls eine entscheidende Rolle bei der Maximierung der antimikrobiellen Leistung.
Dosisabhängige Effekte
Die Wirksamkeit von MgO-Nanopartikeln bei der Hemmung und Abtötung von Bakterien hängt stark von ihrer Konzentration ab, wobei unterschiedliche Schwellenwerte für verschiedene Arten bestehen. Bei grampositiven Bakterien wie S. epidermidis und S. aureus reichen bereits niedrige Konzentrationen (MIC so niedrig wie 0,5–0,7 mg/mL). Gramnegative Bakterien wie E. coli und P. aeruginosa benötigen höhere Dosen – mindestens 1 mg/mL –, um das Wachstum zu hemmen. Besonders E. coli wird bei 0,1 g/mL vollständig gehemmt, mit größeren Hemmhöfen bei höheren Dosen. Mit zunehmender Konzentration vergrößern sich die Hemmhöfe, und die Abtötungsraten steigen deutlich, wobei bei Konzentrationen über 1,6 mg/mL nahezu 100 % der Bakterien abgetötet werden. Hier eine kurze Übersicht:
| Bakterium | Schwellenkonzentration | Wirksamkeit |
|---|---|---|
| S. epidermidis | 0,5 mg/mL | Hemmung |
| E. coli | 100 mg/mL | Vollständige Hemmung |
| P. aeruginosa | 200 μg/mL | Maximale Hemmhöfe |
Wirksamkeitsvariationen
Studien zeigen, dass die antibakterielle Wirksamkeit von MgO-Nanopartikeln erheblich mit Konzentration variiert. Bei niedrigeren Konzentrationen (15,625–1000 μg/mL) sind Hemmungszonen minimal oder fehlen ganz, aber mit steigender Konzentration nimmt die Bakterienhemmung zu. Zum Beispiel erzeugen 20–50 mg/mL messbare Hemmzonen, wobei 0,1 g/mL starke Effekte wie eine 35-mm-Zone gegen E. coli zeigen. Pseudomonas aeruginosa reagiert am besten bei 200 μg/mL, mit größeren Zonen bei zunehmender Konzentration. Verschiedene Herstellungsverfahren und Bakterienstämme beeinflussen die Wirksamkeit ebenfalls; Hydrothermische und Sol-Gel-Nanopartikel bei 50 mg/mL zeigen unterschiedliche Ergebnisse. Insgesamt erhöhen höhere MgO-Werte im Allgemeinen die Bakterienabtötung, aber optimale Effekte hängen vom Stamm, den Eigenschaften der Nanopartikel und dem Anwendungskontext ab. Zusätzlich kann die Aufrüstung von Komponenten, wie z.B. Fahrwerkskomponenten, im Fahrzeug-Tuning die Handhabung und den Fahrkomfort deutlich verbessern – ähnlich wie die Anpassung der MgO-Konzentrationen die antibakterielle Leistung optimiert.
Spektrum der Wirksamkeit: Welche Bakterien werden durch MgO-NPs angegriffen?
Magnesiumoxid-Nanopartikel (MgO-NPs) zeigen eine breitbandige antibakterielle Wirkung, die sowohl Gram-positive als auch Gram-negative Bakterien betrifft. Sie sind wirksam gegen *Staphylococcus aureus*, einschließlich resistenter Stämme wie MRSA, und *Enterococcus faecalis*, die Krankenhausinfektionen verursacht. Außerdem wirken sie gegen *Staphylococcus epidermidis*, was bei Infektionen im Zusammenhang mit medizinischen Geräten relevant ist. Auf der Seite der Gram-negativen Bakterien sind MgO-NPs aktiv gegen *Escherichia coli*, einen häufigen Verursacher von Harnwegs- und Lebensmittelinfektionen, sowie *Pseudomonas aeruginosa*, bekannt für ihre hohe Antibiotikaresistenz. Ihr Wirkmechanismus umfasst Membranzerstörung, oxidativen Stress und die Erzeugung von ROS, was zum Zelltod führt. Diese breite Aktivität unterstützt Anwendungen im Gesundheitswesen, in der Landwirtschaft und in der Industrie.
- Zielgerichtet gegen resistente Stämme wie MRSA und *Pseudomonas aeruginosa*.
- Zerstörung der Zellmembranen beider Bakterientypen.
- Erweiterung auf antifungale Aktivität gegen *Candida*-Arten.
Synthesemethoden und ihre Rolle bei der Verbesserung der antibakteriellen Leistung

Die Synthesemethode, die Sie wählen, bestimmt die Größe, die Oberflächenchemie und die Form von MgO-Nanopartikeln, die alle ihre antibakterielle Wirksamkeit beeinflussen. Kleinere Partikel mit größeren Oberflächen neigen dazu, leichter mit Bakterienzellen zu interagieren und ihre Aktivität zu erhöhen. Durch die Steuerung von Morphologie und Oberflächeneigenschaften während der Synthese können Sie die antibakterielle Leistung von MgO für spezifische Anwendungen optimieren. Grüne Synthesetechniken können die Oberflächenmerkmale weiter modifizieren, die Biokompatibilität verbessern und die Toxizität verringern. Zusätzlich kann die Auswahl geeigneter Synthesebedingungen dazu beitragen, eine konsistente und skalierbare Produktion antibakterieller MgO-Nanopartikel zu erreichen.
Synthese Einfluss auf Größe
Verschiedene Synthesemethoden beeinflussen maßgeblich die Größe von MgO-Nanopartikeln, was wiederum ihre antibakterielle Wirksamkeit beeinflusst. Kleinere Partikel bieten ein höheres Oberflächen-zu-Volumen-Verhältnis, was die Wechselwirkungen mit Bakterien verbessert und die ROS-Produktion steigert. Die Synthesemethode bestimmt auch die Reinheit und Defektdichte der MgO-NPs, was ihre Bioaktivität weiter beeinflusst. 1. Mechanochemische Synthese gefolgt von Hochtemperatur-Glühen erzeugt MgO-Nanopartikel mit etwa 21 nm, wobei die Kristallinität die Aktivität beeinflusst. 2. Hydrothermale Verfahren erzeugen größenjustierbare MgO-Nanopartikel, die häufig im Nanometerbereich liegen und die antibakterielle Wirkung optimieren. 3. Grüne Synthese mittels Pflanzenextrakten führt zu kleineren, gleichmäßigeren Partikeln, dank Phytochemikalien, die als Kappenmittel wirken, was die Bioaktivität erhöht. Diese Variationen zeigen, dass die Wahl des richtigen Syntheseverfahrens direkt die Größe der Nanopartikel und somit die antibakterielle Wirksamkeit beeinflusst. Zusätzlich kann die Energieeffizienz des Syntheseprozesses die Skalierbarkeit und die Umweltverträglichkeit der Nanopartikelproduktion beeinflussen.
Oberflächenchemie Steuerung
Synthesemethoden kontrollieren nicht nur die Größe der MgO-Nanopartikel, sondern gestalten auch deren Oberflächenchemie, die eine entscheidende Rolle für die antibakterielle Leistung spielt. Techniken wie Anodisierung und die Elektrophoretische Abscheidung (EPD) verändern Oberflächeneigenschaften wie Rauheit, Wettability und die Elementzusammensetzung. Anodisierte Proben zeigen eine bessere Haftung an der Grenzfläche, was die Haltbarkeit und die antibakteriellen Effekte in klinischen Anwendungen verbessert. Die Oberflächenchemie beeinflusst die Erzeugung von reaktiven Sauerstoffspezies (ROS), einem Schlüsselmechanismus der bakteriziden Wirkung, insbesondere bei hydrophilen und rauen Oberflächen. Durch die Anpassung der Prozessparameter—Spannung, Dauer, Elektrolyt—kann man die Eigenschaften der Oxidschicht gezielt modifizieren, um die antibakterielle Aktivität zu optimieren. Oberflächenmodifikationen, einschließlich Doping oder Funktionalisierung, verbessern zusätzlich die ROS-Produktion und die Bakterieninteraktion. Letztlich ist die Kontrolle der Oberflächenchemie durch die Synthese entscheidend, um effektive und langlebige antibakterielle MgO-Beschichtungen für biomedizinische Anwendungen zu schaffen. Optimierung der Synthesebedingungen ist entscheidend, um die gewünschten Oberflächeneigenschaften zu erreichen und die antibakterielle Wirksamkeit zu maximieren.
Morphologie und Wirksamkeit
Die Wahl der geeigneten Synthesemethode beeinflusst direkt die Morphologie von MgO-Nanopartikeln, welche wiederum ihre antibakterielle Wirksamkeit bestimmt. Verschiedene Techniken wie Hydrothermalsynthese, grüne Synthese, Mikrowellensynthese und Sol-Gel-Synthese erzeugen unterschiedliche Strukturen, die sich auf Größe, Oberflächenbereich und Kristallinität auswirken. Diese Faktoren verbessern die Interaktion mit bakterielle Membranen und die Erzeugung reaktiver Sauerstoffspezies. Berücksichtigen Sie diese Aspekte, um Ihr Verständnis zu vertiefen:
- Kristallstruktur: Hydrothermale Synthese erzeugt hochkristallines MgO, was die antibakterielle Aktivität steigert.
- Partikelgröße und Oberflächenbereich: Kleinere Partikel (~29,5 nm) mit größerer Oberfläche verbessern die Interaktion mit Membranen und die ROS-Produktion.
- Oberflächenchemie und Dispersion: Die Synthesemethode beeinflusst Oberflächenmodifikationen und Homogenität, was die Wirksamkeit von MgO im Kontakt mit Bakterien beeinflusst.
Praktische Anwendungen von MgO-NPs in Landwirtschaft und Gesundheitswesen

MgO-Nanopartikel (MgO-NPs) werden aufgrund ihrer bemerkenswerten antimikrobiellen, Stressabbau- und wachstumsfördernden Eigenschaften zunehmend in Landwirtschaft und Gesundheitswesen eingesetzt. In der Landwirtschaft fördern sie die Resistenz der Nutzpflanzen gegenüber Stressfaktoren wie Dürre, Salzgehalt und Schwermetallen, indem sie die Pflanzenstrukturen stärken, die Nährstoffaufnahme verbessern und hormonelle sowie antioxidative Abwehrmechanismen aktivieren. MgO-NPs wirken auch als potente antibakterielle Mittel, indem sie Pathogene schädigen und die Krankheitsinzidenz verringern, beispielsweise bei Bakterienwelke und Holzwurmkrankheit. Sie lösen Pflanzenimmuntwege (SA, JA, ET) aus, was die Krankheitsresistenz und die Toleranz gegenüber oxidativem Stress erhöht. Praktisch gesehen steigern MgO-NPs die Keimung von Samen, die Vitalität von Setzlingen und die Photosynthese, was zu höheren Erträgen führt. Zudem verringern sie die Abhängigkeit von chemischen Pflanzenschutzmitteln, bieten umweltfreundliche Krankheitsbekämpfung und unterstützen nachhaltige landwirtschaftliche Praktiken. Außerdem kann das Verständnis für die Leistung von E-Dirtbikes Einblicke darin geben, wie energieeffiziente Systeme wie MgO-NPs zur nachhaltigen Landwirtschaft beitragen.
Sicherstellung der Sicherheit: Balance zwischen Wirksamkeit und Toxizität bei der Verwendung von MgO-Nanopartikeln

Die Balance zwischen den Vorteilen von MgO-Nanopartikeln und ihren potenziellen Risiken erfordert eine sorgfältige Beachtung von Dosierung und Exposition. Es ist wichtig zu verstehen, dass hohe Dosen DNA-Schäden, oxidative Belastung und Organtoxizität, insbesondere in Leber- und Nierentissue, verursachen können. Um die Sicherheit zu gewährleisten, sollten Sie folgende wichtige Punkte beachten:
- Halten Sie die Konzentrationen unter 250 µg/mL, wo die Toxizität minimal bleibt.
- Überwachen Sie Gewebespiegel, um eine toxische Anreicherung zu vermeiden, insbesondere bei klinischem oder umweltbezogenem Einsatz.
- Erkennen Sie an, dass Nanopartikelgröße, Oberflächenchemie und Aggregation die Zellaufnahme und die Toxizitätsgrade beeinflussen.
Aktuelle umwelttoxikologische Studien haben gezeigt, dass MgO-Nanopartikel bei den getesteten Umweltkonzentrationen keinen negativen Einfluss auf das Überleben von Regenwürmern haben, was auf ein geringes ökologisches Risiko hinweist.
Häufig gestellte Fragen
Sind Mgo-Nanopartikel sicher für den menschlichen Verzehr und die Freisetzung in die Umwelt?
Sie fragen sich, ob MgO-Nanopartikel für den menschlichen Verzehr und die Umweltfreisetzung sicher sind. Bei Konzentrationen unter 250 μg/mL zeigen sie im Allgemeinen geringe Toxizität und gelten als sicher, insbesondere für normale Zellen. Allerdings können höhere Dosen zytotoxische Effekte verursachen und Umweltprobleme aufgrund von Metallionenfreisetzung und Bioakkumulation auftreten. Um sicher zu bleiben, sollten Sie die empfohlenen Dosierungslimits einhalten, Schutzmaßnahmen ergreifen und die Umweltauswirkungen sorgfältig überwachen.
Wie beeinflussen Synthesemethoden die antibakteriellen Eigenschaften von MgO-NP?
Sie sehen, Synthesemethoden beeinflussen die antibakteriellen Eigenschaften von MgO-Nanopartikeln erheblich. Zum Beispiel führt die mechanochemische Synthese Partikel hervor, die bakterielle Membranen durch direkten Kontakt und ROS-Generation zerstören. Grüne Synthese mit Pflanzenextrakten verbessert die Oberflächeninteraktionen und steigert die Wirksamkeit. Hydrothermale Verfahren erzeugen Defekte, die die ROS-Produktion erhöhen, und Zink-Doping führt zu Kristalldefekten, die die bakterielle Schädigung verstärken. Diese Variationen beeinflussen Partikelgröße, Oberflächenladung und reaktive Potenziale, was letztlich bestimmt, wie effektiv MgO-NPs Bakterien bekämpfen.
Kann Mgo NPS die Biofilmbildung auf medizinischen Geräten wirksam verhindern?
Stellen Sie sich ein Schutzschild vor, das Bakterien daran hindert, sich niederzulassen – MgO-NPs können genau das auf medizinischen Geräten leisten. Sie hemmen effektiv die Biofilmbildung, indem sie bakterielle Anhaftung stören und Membranen beschädigen, insbesondere bei gramnegativen Bakterien. Kleinere Nanopartikel sind wirkungsvoller und reduzieren die Biofilmmenge, wodurch die Lebensdauer der Geräte verlängert wird. Außerdem machen ihre niedrige Toxizität sie zu einer vielversprechenden, sicheren Option, um Ihre Geräte länger sauber und sicher zu halten.
Was sind die langfristigen Umweltauswirkungen der Verwendung von MgO-Nanopartikeln?
Sie fragen sich nach den langfristigen ökologischen Auswirkungen von MgO-Nanopartikeln. Obwohl sie dabei helfen, Schadstoffe und Schädlinge zu reduzieren, können sie auch Ökosysteme beeinflussen, indem sie Ionen freisetzen und oxidative Belastung erzeugen. Mit der Zeit könnte sich eine Anreicherung negativ auf Bodenmikroben, Wasserlebewesen und Pflanzen auswirken. Um Risiken zu minimieren, ist es wichtig, die Konzentrationen zu überwachen und das Verhalten dieser Partikel in natürlichen Umgebungen zu verstehen, um sicherzustellen, dass sie keine unbeabsichtigten ökologischen Schäden verursachen.
Führen Mgo-Nanopartikel im Laufe der Zeit zu einer Resistenzentwicklung bei Bakterien?
Denke an Bakterien als listige Spieler auf einem Schlachtfeld, die sich ständig anpassen. Derzeit wirken MgO-Nanopartikel wie unaufhörliche Sturmsucher, die physische Schäden verursachen, anstatt genetische Veränderungen hervorzurufen. Sie zielen auf Zellmembranen ab und erzeugen reaktive Sauerstoffspezies, was es für Bakterien schwer macht, Resistenzen zu entwickeln. Während Langzeitstudien begrenzt sind, deuten Hinweise darauf hin, dass diese Nanopartikel weniger wahrscheinlich Resistenzen hervorrufen, was einen vielversprechenden, dynamischen Schutz gegen mikrobiologische Bedrohungen bietet, ohne einen evolutionären Wettlauf zu fördern.
Fazit
Indem Sie die antibakterielle Kraft von MgO verstehen, halten Sie ein leuchtendes Leuchtfeuer im Kampf gegen schädliche Bakterien. Stellen Sie sich MgO-Nanopartikel als winzige Krieger vor, deren Wirksamkeit von ihrer Konzentration und Synthese abhängt. Wenn sie klug eingesetzt werden, können sie Ihr Schutzschild im Gesundheitswesen und in der Landwirtschaft sein. Aber denken Sie daran, wie bei jedem Werkzeug ist Balance der Schlüssel—zu viel Toxizität kann ihr helles Potenzial trüben. Nutzen Sie diese Superkraft vorsichtig und beobachten Sie, wie sie eine sicherere, sauberere Welt erleuchtet.









